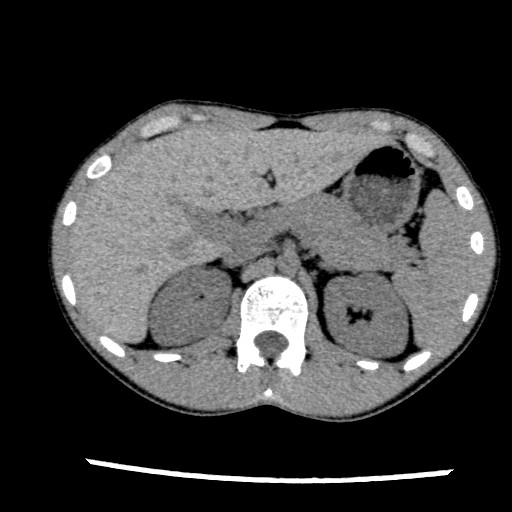

CTとはComputed Tomographyの略で、システムを総称してコンピュータ断層装置と呼ばれます。X線の透過性を利用し、コンピュータを駆使して体内の断面画像を得ることができます。造影剤を使用しない場合を「単純CT検査」、使用する時は「造影CT検査」と言います。検査に要する時間は、部位や状況によって異なりますが、単純で10分程度、単純と造影を両方行った場合15~20分程度です。
CT 検査室の風景
一度で広範囲を撮影することができる装置を使用しており、実際の撮影時間は数秒程度です。しかしその間のわずかな体動(頭部や手足の動き、呼吸の動きなど)でも画像に大きな影響を与え、正確な診断ができなくなってしまいます。そのため当センターでは、体動が生じると思われる患者さんには、眠剤を使用して眠った状態で検査を行います。
眠剤を使用しなくても検査ができる患者さんについても、恐怖心や不安が少しでも和らぐように、内装に工夫を凝らし、壁面や天井に映写装置を設置して、音楽やアニメを見ながら検査を受けられるようにしています。
頭部と腹部の画像です。
CTの基本的な画像で、体を輪切りにしたものです。

上の輪切り画像を、さらにコンピュータ処理することで、さまざまな断面で観察することができ、また、立体的な画像を作ることが可能です。
肺の画像
顔の3D画像
骨の3D画像

心臓周囲の血流部分と気管を描出した3D画像
(造影剤の使用が必須です)
気管と肺の動きを動画にした4D画像
クリックすると動画を再生します(約 400KB/mp4)
小児医療部門
(内科系)
中央診療部門